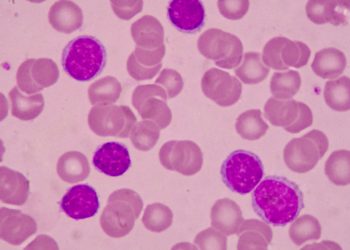
Acute myelogenous leukemia

Qatar is home to numerous top-notch dental clinics offering comprehensive oral care. Whether you’re looking for general dentistry, orthodontics, cosmetic dentistry, or specialized treatments, Qatar’s dental clinics provide advanced technology and exceptional care. Below is a detailed guide to some of the best dental clinics across Qatar, along with answers to frequently asked questions.
Top Dental Clinics in Qatar
1. Tabeebak
- Location: Al Waab
- Services: General dentistry, cosmetic dentistry, orthodontics.
- Features: Online booking and accessible consultation services.
2. Naseem Al Rabeeh Medical Centre
- Branches: Al Maamoura, Al Rayyan, Al Wakrah.
- Services: Comprehensive dental care, including implants, veneers, and orthodontics.
- Highlights: Premium service with modern facilities.
3. Lucida Dental Center
- Location: Al Waab
- Specialty: Cosmetic dentistry and orthodontics.
- Features: Focus on aesthetics with cutting-edge technology.
4. Royal Medical Center
- Branches: Al Hilal, Al Gharrafa.
- Services: General and pediatric dentistry, preventive care.
- Unique Offerings: Customized treatment plans for every patient.
5. British International Dental Centre
- Branches: Al Aziziya, West Bay.
- Specialty: Advanced orthodontic treatments and cosmetic dentistry.
- Features: Highly experienced dentists with international qualifications.
6. Magrabi Eye, ENT, and Dental Center
- Location: D Ring Road
- Specialty: Comprehensive care combining multiple specialties.
- Highlights: Exceptional patient care and multidisciplinary services.
7. Al Maha Dental Clinics
- Location: Al Montazah
- Services: Pediatric and general dentistry.
- Features: Family-friendly clinic with a welcoming environment.
8. Celebrity Medical Center
- Location: Al Duhail
- Specialty: Cosmetic dentistry and restorative treatments.
- Unique Features: Premium services aimed at enhancing smiles.
9. Marble Medical Center
- Location: West Bay, Al Dafna, Lusail, The Pearl
- Specialty: High-end dental care focusing on aesthetic and restorative treatments.
- Highlights: Luxurious setting with personalized care.
Frequently Asked Questions
1. What is the consultation fee for dental clinics in Qatar?
The consultation fee ranges from QAR 100 to QAR 500, depending on the clinic and the nature of the consultation.
2. Are there additional charges when booking appointments through Tabeebak Qatar?
No, Tabeebak Qatar does not charge any additional fees for booking appointments.
3. How can I find dental clinics near me?
By using the Tabeebak Qatar website, you can filter your search based on location to find the closest dental clinics in your area.
4. How can I book appointments with dental clinics in Doha?
Through the Tabeebak Qatar website, you can choose an available date and time slot on the profile of the desired dental clinic to book your appointment online.
5. How does Tabeebak Qatar identify the best dental clinics?
Tabeebak Qatar uses actual patient reviews and ratings to list the best dental clinics in Qatar. Patients rate their experience after every visit, ensuring transparency and reliability.
Why Choose Dental Clinics in Qatar?
- State-of-the-art Technology: Clinics are equipped with the latest dental equipment.
- Highly Qualified Dentists: Many dentists have international certifications and extensive experience.
- Comprehensive Services: From routine cleanings to advanced orthodontics and implants.
- Convenience: Most clinics offer online booking and multiple locations for accessibility.
By leveraging platforms like Tabeebak Qatar, you can effortlessly find and book appointments with Qatar’s leading dental clinics, ensuring a seamless and satisfactory dental care experience.